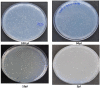

Microbial Mutagenicity Assay: Ames Test
- PMID: 34179285
- PMCID: PMC8203972
- DOI: 10.21769/BioProtoc.2763
Microbial Mutagenicity Assay: Ames Test
Abstract
The Microbial mutagenicity Ames test is a bacterial bioassay accomplished in vitro to evaluate the mutagenicity of various environmental carcinogens and toxins. While Ames test is used to identify the revert mutations which are present in strains, it can also be used to detect the mutagenicity of environmental samples such as drugs, dyes, reagents, cosmetics, waste water, pesticides and other substances which are easily solubilized in a liquid suspension. We present the protocol for conducting Ames test in the laboratory.
Keywords: Carcinogenicity; Gene mutation; Mutagenicity; Revertants; Salmonella strains.
Copyright © 2018 The Authors; exclusive licensee Bio-protocol LLC.
Figures

References
-
- Ames B. N.(1971). The detection of chemical mutagens with enteric bacteria. In: Hollaender, A.(Ed.). Chemical Mutagens, Principles and Methods for Their Detection vol. 1. Plenum pp: 851-863.
-
- Ames B. N., McCann J. and Yamasaki E.(1975). Methods for detecting carcinogens and mutagens with the Salmonella/mammalian-microsome mutagenicity test . Mutat Res 31(6): 347-364. - PubMed
LinkOut - more resources
Full Text Sources

